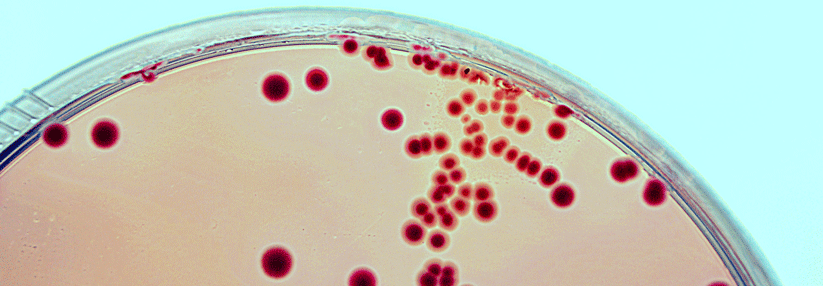

Antibiose bei Zirrhose: potenzieller Lebensretter mit schweren Nebenwirkungen
 Zirrhosepatienten mit Aszites können durch Antibiotika zu 30–80 % vor einer spontanen bakteriellen Peritonitis bewahrt werden.
© wikimedia/Drahreg01; wikipedia/James Heilman
Zirrhosepatienten mit Aszites können durch Antibiotika zu 30–80 % vor einer spontanen bakteriellen Peritonitis bewahrt werden.
© wikimedia/Drahreg01; wikipedia/James Heilman
Ein flammendes Plädoyer für Antibiotika bei Risikozirrhotikern zur Prävention einer spontanen bakteriellen Peritonitis (SBP) hielt Privatdozent Dr. Tony Bruns von der Klinik für Gastroenterologie, Hepatologie und Infektiologie am Universitätsklinikum Jena. In der größten Gefahr schweben Patienten, die schon einmal eine SBP hatten, erklärte der Kollege. Das Rezidivrisiko innerhalb eines Jahres liegt einer Studie zufolge bei 68 %. Mit antibiotischer Prophylaxe sinkt es auf 20 %. Viele weitere Studien zeigten zudem einen erheblichen Abfall der Mortalität in diesem Kollektiv unter der Medikation.
Eine weitere wichtige Gruppe sind Zirrhotiker mit gastrointestinaler Blutung. Bei ihnen mindern…
Bitte geben Sie Ihren Benutzernamen und Ihr Passwort ein, um sich an der Website anzumelden.